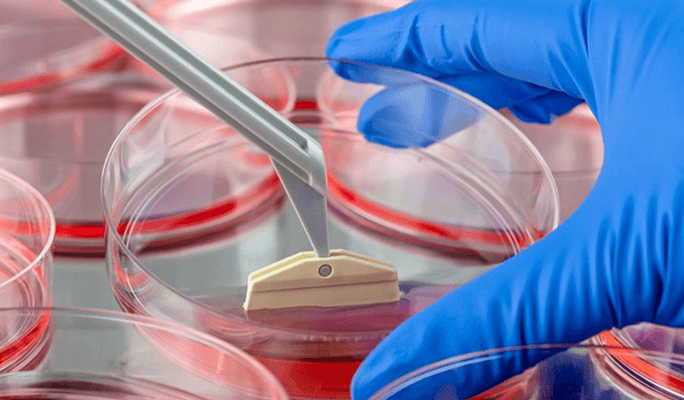
Stem Cell Infusion

Stem Cell Therapy in Panama: Top Hospitals, Cost & Doctors
Find top hospitals, expert specialists, and affordable packages for Stem Cell Therapy in Panama. Real patients, verified results.
91+
Procedures
JCI Accredited
Clinics
ISAPS Verified
Surgeons
ISO Certified
Hospitals
No Hidden
Costs
Secure &
Private
Overview
Stem Cell Therapy in Panama — why patients choose this destination
Panama has become one of the leading destinations for stem cell therapy, attracting thousands of international patients every year. With internationally accredited hospitals, highly experienced specialists, and costs up to 70% lower, Panama offers world-class stem cell therapy without the long wait times or high price tags.
Hospitals in Panama are equipped with the latest medical technology and staffed by surgeons who have trained at top institutions globally. Many facilities offer dedicated international patient departments with multilingual coordinators, airport transfers, and all-inclusive treatment packages.
50+
Verified Hospitals
70%
Cost Savings
JCI
Accredited
24/7
Patient Support
Top Stem Cell Therapy Procedures
Popular procedures available in Panama

Embryonic Stem Cell Therapy
Learn More
Stem Cell Treatment for Ovarian Rejuvenation
Learn More
Placenta Stem Cell Therapy
Learn More
Adult Stem Cell Therapy
Learn More
Umbilical Cord Stem Cell Therapy
Learn More
Cartilage Regeneration Stem Cell Therapy
Learn More
Stem Cell Treatment for Developmental Delay
Learn More
Stem Cell Infusion
Learn MoreWorld’s No. 1 Medical Discovery Platform
CureMeAbroad
Is Absolutely Free
Access exclusive hospital rates with zero service fees.
Get an expert by your side for the entire journey—at no cost to you.
Get Free Consultantion
Schedule Now
Access exclusive hospital rates with zero service fees.
Get an expert by your side for the entire journey—at no cost to you.
Why Choose Panama for Stem Cell Therapy?
Panama is a leading medical tourism hub — here's why patients choose it
Up to 70% Cost Savings
Stem Cell Therapy in Panama costs significantly less than in Western countries — without compromising on quality.
JCI & Internationally Accredited Hospitals
Top hospitals in Panama hold international accreditations ensuring world-class safety and care standards.
Highly Experienced Specialists
Panama is home to specialists with international training and thousands of Stem Cell Therapy procedures performed.
All-Inclusive Medical Tourism
Combine your Stem Cell Therapy with a full recovery in Panama — flights, accommodation & aftercare included.
Frequently Asked Questions
Stem Cell Therapy in Panama — common questions answered
Stem Cell Therapy in Panama is significantly more affordable compared to Western countries. Costs vary by clinic and complexity — contact us for a free quote.
Yes. Panama is one of the world's top medical tourism destinations with internationally accredited hospitals, English-speaking staff, and high patient satisfaction rates.
Look for JCI-accredited hospitals with experienced Stem Cell Therapy specialists. CureMeAbroad has verified hospitals across Panama. Use our platform to compare profiles and book a free consultation.
Recovery timelines vary by procedure. We recommend staying for at least 7–14 days post-treatment to allow for initial recovery and follow-up consultations before flying home.
Medical packages typically include consultation, the procedure, hospital stay, post-op care, and follow-up visits. Some packages also include airport transfers and accommodation.
Still have questions?
Our medical team is here to help — get a free consultation
Medically Reviewed
Verified Content
CureMeAbroad Medical Review Team
Help Me Plan
My
Stem Cell Therapy Abroad
Access exclusive hospital rates with zero service fees. Get an expert by your side for the entire journey—at no cost to you.

Book Your Free Medical Consultation
Get expert advice—free and easy. Start your healthcare journey today.